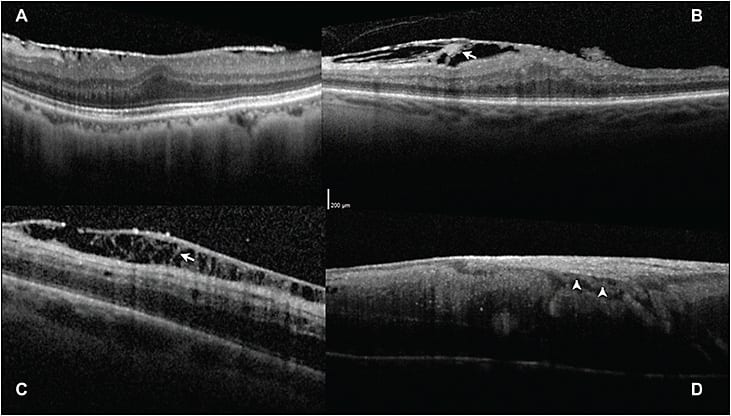

Multimodal Imaging: Redefining Retinal Disease With Current Technology
Combined imaging changes disease paradigms.
ERIC J. SIGLER, MD
Ophthalmic imaging has long been a mainstay of the diagnosis and treatment of eye disease. This aspect of retinal specialists’ practice has undergone many recent advances, leading to an expanding structural understanding of disease processes. The combination of multiple imaging modalities has helped retinal physicians to further understand disease progression and treatment response.
In the era of multimodal imaging, recent observations have helped to clarify the underlying pathogenesis of many retinal diseases. Each imaging “modality” has tissue-specific characteristics that have allowed for the redefinition of many common retinal conditions and have led to an evolution of our understanding of vitreoretinal diseases.
In this fashion, spectral-domain optical coherence tomography (SD-OCT), widefield angiography, peripheral OCT, and intraoperative visualization are changing our understanding of retinal diseases.
MULTIMODAL IMAGING
Optical coherence tomography was introduced in the early 1990s and provided the first cross-sectional morphologic analysis of the macula. SD-OCT followed and became widespread, concomitant with the emergence of anti-VEGF therapy. It has since been adopted as a common standard by which medical retinal disease is managed clinically.
Eric J. Sigler, MD, practices with Ophthalmic Consultants of Long Island in Rockville Centre, NY. He reports no financial interests in any products mentioned in this article. Dr. Sigler can be reached via e-mail at ejsigler@gmail.com.
Recently, higher resolution of morphologic features has led to the identification of new retinal anatomic variations and improved clinical management. In addition, peripheral visualization provided insight involving both medical and surgical retinal diseases, evident with peripheral OCT and widefield angiography. Widefield angiography, in turn, has offered early findings in retinal vascular disease, particularly when peripheral ischemia and neovascularization are present.
Angiography is now capable of imaging the entire extent of the retinal circulation, and it is particularly useful for cases in which posterior-pole findings are absent but vascular disease is suspected, as in Figure 1. Multimodal imaging has been applied to both medical and surgical retinal disease, and new findings have offered insight into underlying pathogeneses.

Figure 1. Widefield angiography in retinal vascular disease with center-periphery mismatch pathology. A) A 47-year-old male smoker with no previous history of diabetes; examination revealed microaneurysms without edema, while widefield angiography discloses diffuse peripheral neovascularization and ischemia. B) A 15-year-old with sickle cell retinopathy; posterior-pole examination was unremarkable, but widefield angiography reveals the extent of the proliferative disease. Images obtained with RetCam (Clarity Medical Systems, Pleasanton, CA).
AGE-RELATED MACULAR DEGENERATION
New aspects of age-related macular degeneration that are beginning to be elucidated are the specific structural elements of retinal and retinal pigment epithelium degeneration. Recent imaging in AMD has included fundus autofluorescence, widefield angiography, and enhanced-depth SD-OCT.1
Drusen characteristics have been demonstrated in not only the typically recognized locations of intra- and sub-RPE, however; cross-sectional analysis has identified reticular pseudodrusen as subretinal drusenoid material.2
Previously recognized as a drusen subtype, reticular pseudodrusen are now considered a distinct subretinal entity and are associated with increased risk of progression to late AMD.3 Histopathologic and adaptive optics analysis has demonstrated the clinical correlation of subretinal drusenoid deposits as areas of degenerating photoreceptors,4,5 and they may be associated with a thin choroid6 and risk of choroidal neovascularization and geographic atrophy.7
RAP Lesions
Additionally, retinal angiomatous proliferation (RAP) has been further characterized as a distinct intraretinal neovascular process in AMD.8 Early RAP lesions may now be identified as dilated midretinal vessels with small intraretinal cysts.
With the roughly 3- to 5-µm resolution of SD-OCT, structures such as distinct, isolated midretinal vasculature can be visualized. The lesions can be successfully treated with anti-VEGF therapy. These lesions commonly cause intraretinal fluid as the primary SD-OCT sign of exudation.
The author has treated patients with this early finding in a temporal perifoveal location with small (60-µm spot), low-energy, short-duration focal laser photocoagulation without anti-VEGF therapy. Complete resolution of the intraretinal RAP was achieved in its early stage in two patients and is the subject of a forthcoming paper.
The choroid is a structure that has long been hypothesized to contribute to retinal disease; however, its structural analysis was previously limited to indocyanine green (ICG) angiography and ultrasound. With the development of enhanced-depth SD-OCT,1 visualization of choroidal structure and thickness has become a feasible component of the posterior-segment examination.
Choroidal Thickness
While choroidal thickness is not necessarily related to choroidal blood flow, it plays a significant role in providing oxygen to the RPE and outer retina, making it an attractive candidate for evaluating degenerative chorioretinal disease, particularly AMD.
We evaluated patients with early AMD and age-matched normal subjects and found a significantly thinner choroid in AMD.9 Furthermore, we hypothesized that the well-known increased risk of CNV and advanced AMD in smokers may have an underlying vascular etiology.10 We demonstrated that this risk may be correlated with a significantly reduced choroidal thickness in smokers.
The author has theorized that a further structural component, such as selective loss of the choriocapillaris and short posterior ciliary artery atherosclerosis, may contribute to some AMD phenotypes, which would be consistent with the previously described association of choroidal thickness, subretinal drusenoid deposits, and other forms of progressive AMD.
Recently, we identified localized RPE elevations that correspond to specific medium-sized choroidal vessels, which the author has termed focal choroidal elevations (FCLs; Figure 2). Using multimodal imaging, we localized these macular lesions to the short posterior ciliary arteries and efferent Sattler layer vessels.

Figure 2. Multimodal imaging of focal choroidal elevations in AMD. A) Amsler grid demonstrating metamorphopsia drawn by this 86-year-old female patient; B) Right eye fundus autofluorescence with no evidence of geographic atrophy but a faint pinpoint area of relative hypoautofluorescence (arrowhead) corresponding to focal choroidal elevation. C) Scanning laser ophthalmoscopic image with green arrow showing raster position for SD-OCT. D) Focal choroidal elevation (arrow) corresponds to the location of metamorphopsia; there is subtle disruption of the ellipsoid zone overlying this region (arrowhead). Images obtained with Heidelberg OCT (Franklin, MA).
Anecdotally, the author has identified many patients with long-standing diagnoses of AMD by their primary eyecare providers, who have actually had a thin choroid and FCL alone. Ongoing structural analysis has demonstrated that these sub-RPE vessels often have a lumen diameter between 120 and 150 µm, and we have observed several patients in whom type 1 and type 2 CNV have arisen from previously identified FCLs.
It is well known that CNV always arises from existing vessels; however, the localization of these lesions as new structural lesions that may be identified prior to visually significant neovascular disease therefore makes them an attractive target for observation and preventive treatment.
COATS DISEASE
Due to our recent ability to perform intraoperative widefield angiography and intraoperative Doppler SD-OCT, new findings have led to further characterization of macular lesions in Coats disease.
We prospectively performed multimodal imaging in childhood Coats disease11 and have reappraised the previously described “macular fibrosis.”12 This lesion, which was originally thought to involve the choroid, based on examination and histopathology,13 was observed prior to widespread knowledge regarding CNV and the disciform process. Therefore, popular theories regarding its nature were thought to be secondary only to chronic disease and cicatricial changes secondary to chronic subretinal exudate.
Using angiography and intraoperative Doppler SD-OCT in its early stages, we identified this lesion as RAP and chorioretinal anastomosis (ie, a neovascular process).11 This lesion is present in roughly 20% of children with early Coats disease, further supporting the use of anti-VEGF therapy, and it is demonstrated in Figure 3.

Figure 3. Multimodal imaging in retinal angiomatous proliferation and chorioretinal anastomosis in childhood Coats disease. A) Widefield intraoperative angiography in a child with Coats disease with typical chorioretinal anastomosis and PED characteristic of type 3 choroidal neovascularization (arrow). B) Retinal vessels (arrow) disappearing into the fovea of a patient with Coats disease on SD-OCT. C) Doppler overlay demonstrating chorioretinal anastomosis (arrow) and choroidal neovascularization. D) Additional Doppler SD-OCT in patient with Coats disease and chorioretinal anastomosis (arrow). Images obtained with Heidelberg OCT and Bioptigen Doppler OCT (Research Triangle Park, NC).
DIFFERENTIATING MECHANICAL AND MEDICAL MACULAR PATHOLOGY
Vasogenic macular edema is a common medical cause of vision loss. This process is divided into two general categories: inflammatory and ischemic (VEGF driven). Although corticosteroids improve the condition in inflammatory macular edema, they have poor efficacy and limited effects in ischemic processes, compared with anti-VEGF therapy.
We recently demonstrated a specific structural pattern of inflammatory macular edema, particularly in pseudophakic cystoid macular edema,14 which is similar to additionally identified patterns in other forms of uveitis. SD-OCT can be used to determine active disease with inner nuclear layer (INL) involvement.
Furthermore, isolated subretinal fluid with persistent reduction in visual acuity is a finding indicating resolving CME with a return to eventual improvement. Fluorescein angiography remains important for observing vascular beds, disc leakage, and the isolated macular leakage of chronic CME.
The author has observed both aneurysm formation and vasogenic edema from ischemia and vascular degeneration originating in the INL, and we believe that this layer may be used as a predictor of disease activity in many edematous processes, providing a useful, instantaneous way of assessing disease activity while viewing SD-OCT.
In the context of epimacular traction, such as epiretinal membrane and vitreomacular traction, dilated midretinal capillaries may be useful in further differentiating mechanical and medical macular pathologies.
Prior to the development of SD-OCT, there was considerable overlap between angiographic vasogenic edema and structural angiographic leakage. SD-OCT has identified specific retinal structural characteristics that differentiate the two processes.
Most importantly, the presence of even subtle epimacular tractional pathology lead to changes in cross-sectional appearance. Epimacular contour changes and foveal inversion (effacement of the foveal depression) are signs of tractional pathology.
Altered foveal contour without thickening or epimacular contour changes have been identified in lamellar macular hole, and isolated outer plexiform layer cystic cysts (“macular schisis”) are common mechanical variations in the macular structure that rarely have significant visual impact and have recently been identified.
Epimacular Structures
Epimacular membrane structure can be viewed in much greater detail than previously possible with SD-OCT. We have identified two structural features that are helpful in clinical management. First, a dynamic process may occur in the context of epimacular membrane that has been rarely previously reported. We characterized this phenomenon as an epimacular membrane rip15 or splitting that occurs within idiopathic epimacular membrane, which may be associated with an acute decline in VA, particularly when type 1, or fovea-involving.
Second, we differentiated the SD-OCT appearance of idiopathic or vitreous membranes and ERM present in proliferative vitreoretinopathy (likely gliosis).16 The ERM present in PVR, or in patients with previous retinal breaks, regardless of previous treatments, demonstrates finger-like projections spanning the retinal surface and membrane (Figure 4). In contrast, patients with idiopathic (likely simply vitreous) epimacular membrane did not demonstrate this finding.
Figure 4. Differentiating epimacular membrane using SD-OCT morphology. A) Patient with typical idiopathic epimacular membrane with a single hyper-reflective line, likely vitreous on the macular surface. B) Patient with macular PVR, or epimacular membrane in the context of previously untreated retinal breaks, with finger-like projections spanning the retina and membrane (arrow). C) Patient with multiple previous vitrectomies and perimacular PVR in an area of previous ILM peeling, demonstrating distinct finger-like projections spanning epiretinal membrane. D) Vascularized epimacular membrane in a patient with a retinal vasoproliferative tumor, demonstrating a blood vessel (arrow) between its inner surface and the nerve fiber layer. Images obtained with Heidelberg OCT.
Anecdotally, the author has also observed that the internal limiting membrane is frequently removed concomitant with membrane peeling in macular PVR, and it typically requires secondary peeling in idiopathic (vitreous or “non-PVR”) cases.
We have therefore hypothesized that some epimacular membrane is simply the floor of the precortical vitreous pocket that has remained adherent to the macula following a vitreous cortex separation and undergoes secondary “hyalinization.” This finding in contrast to PVR cases, in which gliosis is also present. This notion is the subject of a forthcoming clinicopathologic correlation.
VITREORETINAL SURGERY
Vitreoretinal surgery is an area that continues to evolve and has perhaps the least consistent agreement among retinal specialists regarding technique and quality standards. This area is fraught with misconception, in large part due to visualization and variable understanding of surgical anatomy, compared to the limited amount of histologic data available, as well as the difficulty with imaging the peripheral retina.
Recently, peripheral SD-OCT has been used to elucidate the structural morphology of whitening without pressure, which is probably now better termed “outer retinal whitening” (ORW). We identified a hyper-reflectant band corresponding to the ellipsoid zone of the inner photoreceptor segments,17 demonstrated in Figure 5. This band has some similar features to the SD-OCT characteristics present in commotio retinae; however, there is preservation of a distinct line in ORW.

Figure 5. Peripheral multimodal imaging of “white without pressure.” A) Peripheral color photography demonstrating a relatively darker area in a region of white without pressure. B) SLO image of the region demonstrating scan position for SD-OCT. C) SD-OCT, showing a distinct hyper-reflective band at the ellipsoid zone, which is seen to abruptly end at the border of the outer retinal whitening. Images obtained with RetCam and Heidelberg OCT.
This modality is also helpful for differentiating retinoschisis from subretinal fluid present in a retinal detachment. With peripheral OCT, we have identified partial thickness retinal breaks following posterior vitreous detachment or operculated schisis arising from areas of previous retinal tufts.
Intraoperative SD-OCT has become available on multiple platforms. This modality is an attractive method to visualize intraoperative anatomy, and it has been suggested that it may obviate the need for vitreoretinal marking or staining and identify tissue planes for dissection.
Unfortunately, the greatest strength of office-based OCT, its use of light through clear biologic media, is the greatest weakness of intraoperative OCT. Shadowing of instruments through the axis of focus makes it currently impossible to view the point of contact and angle of attack of instrumentation, such as scissors or forceps, thus limiting the need for the intraoperative OCT and hindering its decision-making utility.
The identification of pre- and post-task anatomy may prove helpful in the near future, such as identifying “entry points” into hyaloidal spaces, for inside-out delamination and access-segmentation in traction retinal detachments. Visualization of small or diffuse areas of subretinal fluid in retinal reattachment may be similarly useful.
FUTURE DIRECTION AND NEW MODALITIES
Many additional imaging modalities are becoming available that may offer additional imaging functions or improvements to currently available devices. Swept-source OCT has emerged as a method to capture both larger areas of the posterior segment and enhanced depth, which may advance our understanding of perimacular and peripheral lesions.18
In addition to Doppler OCT, OCT angiography19 is now possible and may become an important part of imaging posterior-segment vascular beds. Surgical imaging and visualization will continue to be important factors in future quality and efficiency and will continue to improve.
CONCLUSION
Multimodal imaging has led to remarkable recent insight and a more complete understanding and redefinition of vitreoretinal diseases. The major challenge to this progress is resolving the need for more imaging modalities with our climate of declining healthcare reimbursement. Although many exciting advances (such as OCT angiography) are now possible, their widespread use may be limited by the failure by insurance companies to recognize the need for new or additional imaging.
The author advocates an imaging algorithm with initial SD-OCT for visually significant suspected retinal disease. Any unknown variables required for diagnosis are further evaluated with appropriate imaging, such as angiography. Once venipuncture is performed for FA, ICG angiography may be helpful and is added in the presence of RPE pathology noted on exam, autofluorescence, or OCT. In this manner, testing is minimized, but thoroughness is emphasized for rapid, accurate diagnosis and treatment.
Exam, SD-OCT, and FAF are the only methods required for follow-up in most vitreoretinal diseases. Peripheral OCT and widefield angiography are modalities that will become standard portions of the posterior-segment evaluation. RP
REFRENCES
1. Spaide RF, Koizumi H, Pozzoni MC. Enhanced depth imaging spectral-domain optical coherence tomography. Am J Ophthalmol. 2008;146:496-500.
2. Zweifel SA, Spaide RF, Curcio CA, Malek G, Imamura Y. Reticular pseudodrusen are subretinal drusenoid deposits. Ophthalmology. 2010;117:303-312.
3. Zweifel SA, Imamura Y, Spaide TC, Fujiwara T, Spaide RF. Prevalence and significance of subretinal drusenoid deposits (reticular pseudodrusen) in age-related macular degeneration. Ophthalmology. 2010;117:1775-1781.
4. Oak AS, Messinger JD, Curcio CA. Subretinal drusenoid deposits: further characterization by lipid histochemistry. Retina. 2014;34:825-826.
5. Meadway A, Wang X, Curcio CA, Zhang Y. Microstructure of subretinal drusenoid deposits revealed by adaptive optics imaging. Biomed Opt Express. 2014;5:713-727.
6. Mrejen S, Spaide RF. The relationship between pseudodrusen and choroidal thickness. Retina. 2014;34:1560-1566.
7. Spaide RF. Outer retinal atrophy after regression of subretinal drusenoid deposits as a newly recognized form of late age-related macular degeneration. Retina. 2013;33:1800-1808.
8. Freund KB, Ho IV, Barbazetto IA, et al. Type 3 neovascularization: the expanded spectrum of retinal angiomatous proliferation. Retina. 2008;28:201-211.
9. Sigler EJ, Randolph JC. Comparison of macular choroidal thickness among patients older than age 65 with early atrophic age-related macular degeneration and normals. Invest Ophthalmol Vis Sci. 2013;54:6307-6313.
10. Sigler EJ, Randolph JC, Calzada JI, Charles S. Smoking and choroidal thickness in patients over 65 with early-atrophic age-related macular degeneration and normals. Eye (Lond). 2014;28:838-846.
11. Sigler EJ, Calzada JI. Retinal angiomatous proliferation with chorioretinal anastomosis in childhood Coats disease: a reappraisal of macular fibrosis using multimodal imaging. Retina. 2015;35:537-546.
12. Jumper JM, Pomerleau D, McDonald HR, Johnson RN, Fu AD, Cunningham ET Jr. Macular fibrosis in Coats disease. Retina. 2010;30(Suppl):S9-S14.
13. Coats G. Forms of retinal diseases with massive exudation. R Lond Ophthalmol Hosp Rep. 1908;17:440-525.
14. Sigler EJ, Randolph JC, Kiernan DF. Longitudinal analysis of the structural pattern of pseudophakic cystoid macular edema using multimodal imaging. Graefes Arch Clin Exp Ophthalmol. 2016;254:43-51.
15. Sigler EJ, Randolph JC, Calzada JI. Incidence, morphology, and classification of epimacular membrane rip. Retina. 2013;33:1158-1165.
16. Sigler EJ, Randolph JC, Calzada JI. Comparison of morphologic features of macular proliferative vitreoretinopathy and idiopathic epimacular membrane. Retina. 2014;34:1651-1657.
17. Diaz RI, Sigler EJ, Randolph JC, Rafieetary MR, Calzada JI. Spectral domain optical coherence tomography characteristics of white-without-pressure. Retina. 2014;34:1020-1021.
18. Hirata M, Tsujikawa A, Matsumoto A, et al. Macular choroidal thickness and volume in normal subjects measured by swept-source optical coherence tomography. Invest Ophthalmol Vis Sci. 2011;52:4971-4978.
19. Matsunaga D, Yi J, Puliafito CA, Kashani AH. OCT angiography in healthy human subjects. Ophthalmic Surg Lasers Imaging Retina. 2014;45:510-515.








